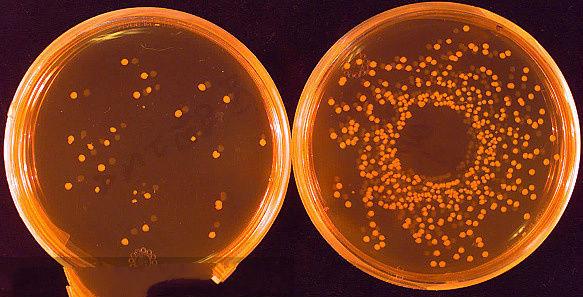
如果孩子在家里饿死了怎么办,如果有小孩腹泻吃什么药

想要小孩安,三分饥和寒。
意思是为了保障孩子的健康,平时不要给孩子吃得过饱,不要穿得太多,否则容易出现小儿积食,免疫力差的问题。
但如何吃得好,对于家长来说无疑是一件相对困难的事。
因为只要一不小心,就会引起孩子出现肠胃不舒服、腹泻等问题。

腹泻,是一种小儿常见的疾病之一,其主要特点为大便次数增多和大便的性状发生改变,多是因为病原体、多因素引起的腹泻,一般都能够痊愈。
为什么说多病原都能够导致婴幼儿出现腹泻问题呢?主要是以下几方面
1. 肠胃炎
肠胃型感冒,是一种常见的疾病,主要是轮状病毒感染导致,也是引起腹泻、胃痉挛、低烧、呕吐的常见病因。
2. 细菌感染
除了病毒感染之外,细菌感染也是常见的感染病因之一,如著名的沙门氏菌、大肠杆菌等,当感染时,会给患者带来呕吐、腹痛血便、发烧等问题。
3. 寄生虫感染
微生物、寄生虫感染,都会引起腹泻,他们会寄生在婴幼儿的肠道中,引起腹泻问题。
4. 药物因素
部分抗生素药物在治疗期间,有可能出现腹泻的副作用,一般停药之后症状即有缓解。
5. 食物因素
孩子在进食生冷食物、更换奶粉、喝太多含糖制品时,也会引起孩子腹泻的问题出现。
面对腹泻问题,我们应该针对腹泻的程度,来采取不同的措施来缓解腹泻问题,严重时,还必须及时就医。
轻微腹泻,往往症状较轻,无脱水中毒症状,没有发热,精神良好,食欲正常,没有饥饿感,一般几天后就会恢复。

中度腹泻,会出现一定的脱水和轻度中度症状。当出现轻微腹泻伴有呕吐的时候,为了防止脱水,可适当使用一些补盐液来补充身体缺失的水分,以防出现脱水和电解质紊乱的问题,建议使用(博叶)口服补液盐这种低渗型的ORS配方,通过调节肠道水、电解质代谢平衡,来达到快速补液、安全止泻的效果,同时还能够减少呕吐和减少粪便量,缩短腹泻病程。
而当症状加重,变成重度脱水时,孩子会出现烦躁、精神萎靡、嗜睡、面色苍白、高热等症状,如果孩子每1~2小时就排一次水样便,甚至频率更高,出现了脱水症状,则应及时带孩子就医治疗。